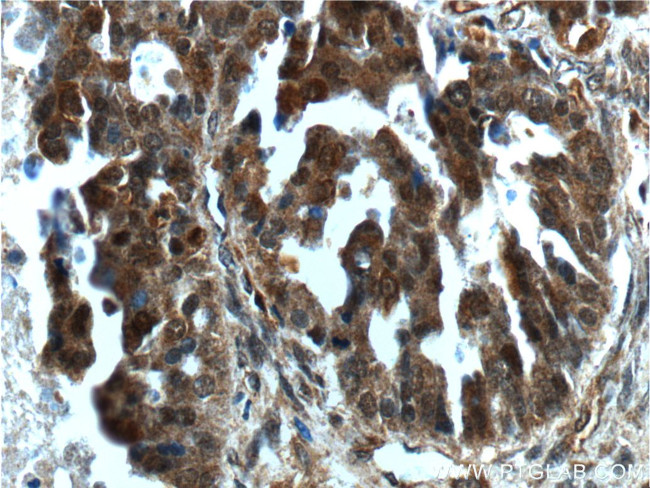
SALL4 Antibody in Immunohistochemistry (Paraffin) (IHC (P))
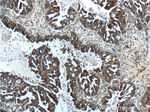
SALL4 Antibody in Immunohistochemistry (Paraffin) (IHC (P))

Search
Proteintech
SALL4 Polyclonal Antibody
{{$productOrderCtrl.translations['antibody.pdp.commerceCard.promotion.promotions']}}
{{$productOrderCtrl.translations['antibody.pdp.commerceCard.promotion.viewpromo']}}
{{$productOrderCtrl.translations['antibody.pdp.commerceCard.promotion.promocode']}}: {{promo.promoCode}} {{promo.promoTitle}} {{promo.promoDescription}}. {{$productOrderCtrl.translations['antibody.pdp.commerceCard.promotion.learnmore']}}
产品信息
24500-1-AP
种属反应
已发表种属
宿主/亚型
分类
类型
抗原
偶联物
形式
浓度
规格
纯化类型
保存液
内含物
保存条件
运输条件
产品详细信息
Immunogen sequence: MSRRKQAKP QHINSEEDQG EQQPQQQTPE FADAAPAAPA AGELGAPVNH PGNDEVASED EATVKRLRRE ETHVCEKCCA EFFSISEFLE HKKNCTKNPP VLIMNDSEGP VPSEDFSGAV LSHQPTSPGS KDCHRENGGS SEDMKEKPDA ESVVYLKTET ALPPTPQDIS YLAKGKVANT NVTLQALRGT KVAVNQRSAD ALPAPVPGAN SIPWVLEQIL CLQQQQLQQI QLTEQIRIQV NMWASHALHS SGAGADTLKT LGSHMSQQVS AAVALLSQKA GSQGLSLDAL KQAKLPHANI PSATSSLSPG LAPFTLKPDG TRVLPNVMSR LPSALLPQAP GSVLFQSPFS T (1-350 aa encoded by BC111714)
靶标信息
Sall4 protein is encoded by the Sall4 gene located on chromosome 20 in humans and belongs to the Spalt-like protein family. It plays an important role in somatic stem cell maintenance and is studied as a stem cell biomarker. It is a zinc finger transcription factor that is upregulated during development and shown to interact with Oct4 and Sox2. It also forms a complex with Nanog to maintain the pluripotency of Embryonic Stem cells (ESCs). Several current research studies focus on its function as an oncogene and tumor biomarker. Some of the reported target genes of Sall4 include p53, Bmi-1, Bcl2 and XIAP.
仅用于科研。不用于诊断过程。未经明确授权不得转售。
生物信息学
蛋白别名: dJ1112F19.1; sal-like 4; Sal-like protein 4; spalt-like transcription factor 4; Zinc finger protein 797; Zinc finger protein SALL4
基因别名: DRRS; HSAL4; IVIC; SALL4; ZNF797
UniProt ID: (Human) Q9UJQ4
Entrez Gene ID: (Human) 57167, (Rat) 686412